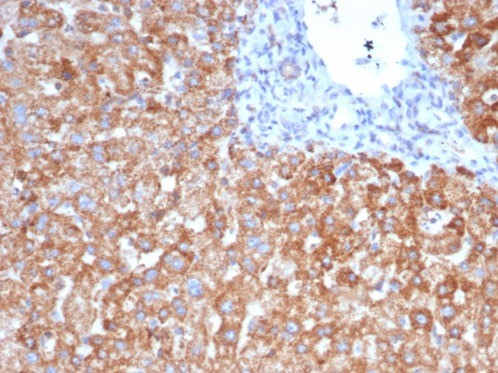
VEGF Antibody (VEGFA/7636R) - Azide and BSA Free

VEGF Antibody (VEGFA/7636R) - Azide and BSA Free
Novus Biologicals, part of Bio-Techne | Catalog # NBP3-20875
Recombinant Monoclonal Antibody

Conjugate
Catalog #
Key Product Details
Species Reactivity
Human
Applications
Immunohistochemistry-Paraffin
Label
Unconjugated
Antibody Source
Recombinant Monoclonal Rabbit IgG1 kappa Clone # VEGFA/7636R
Format
Azide and BSA Free
Concentration
1 mg/ml
Product Specifications
Immunogen
Recombinant fragment (around aa1-200) of human VEGF protein (exact sequence is proprietary)
Localization
Cytoplasm. Cell surface. Extracellular (secreted).
Specificity
This monoclonal antibody is highly specific to VEGF, which is a homodimeric, disulfide-linked glycoprotein with a close homology to platelet derived growth factor (PDGF) There are multiple isoforms of VEGF containing 206-, 189-, 165-, and 121-amino acid residues
Clonality
Monoclonal
Host
Rabbit
Isotype
IgG1 kappa
Description
Positive Controls: Tumor cells in astrocytomas, breast or ovarian carcinomas.
Antibody with azide - store at 2 to 8C. Antibody without azide - store at -20 to -80C. Non-hazardous. No MSDS required.
Antibody with azide - store at 2 to 8C. Antibody without azide - store at -20 to -80C. Non-hazardous. No MSDS required.
Scientific Data Images for VEGF Antibody (VEGFA/7636R) - Azide and BSA Free
VEGF Antibody (VEGFA/7636R)
Formalin-fixed, paraffin-embedded human liver stained with VEGF antibody (VEGFA/7636R). Inset: PBS instead of primary antibody; secondary only negative control.VEGF Antibody (VEGFA/7636R)
Formalin-fixed, paraffin-embedded human heart stained with VEGF antibody (VEGFA/7636R). HIER: Tris/EDTA, pH9.0, 45min. Secondary: HRP-polymer, 30min. DAB, 5min.VEGF Antibody (VEGFA/7636R)
Formalin-fixed, paraffin-embedded human placenta stained with VEGF antibody (VEGFA/7636R). Inset: PBS instead of primary antibody; secondary only negative control.Applications for VEGF Antibody (VEGFA/7636R) - Azide and BSA Free
Application
Recommended Usage
Immunohistochemistry-Paraffin
1-2 ug/ml
Application Notes
Immunohistochemistry (Formalin-fixed): 1-2ug/ml for 30 minutes. at RT. Staining of formalin-fixed tissues requires heating tissue sections in 10mM Tris with 1mM EDTA, pH 9.0, for 45 min at 95C followed by cooling at RT for 20 minutes.
Optimal dilution for a specific application should be determined.
Optimal dilution for a specific application should be determined.
Formulation, Preparation, and Storage
Purification
Protein A or G purified
Formulation
10mM PBS
Format
Azide and BSA Free
Preservative
No Preservative
Concentration
1 mg/ml
Shipping
The product is shipped with polar packs. Upon receipt, store it immediately at the temperature recommended below.
Stability & Storage
Store at -20 to -70C. Avoid freeze-thaw cycles.
Background: VEGF
References
1. Melincovici CS, Bosca AB, susman S, et al. Vascular endothelial growth factor (VEGF) - key factor in normal and pathological angiogenesis. Rom J Morphol Embryol. 2018;59(2):455-467.
2. Shaik F, Cuthbert GA, Homer-Vanniasinkam S, Muench SP, Ponnambalam S, Harrison MA. Structural Basis for Vascular Endothelial Growth Factor Receptor Activation and Implications for Disease Therapy. Biomolecules. 2020;10(12):1673. https://doi.org/10.3390/biom10121673
3. Apte RS, Chen DS, Ferrara N. VEGF in Signaling and Disease: Beyond Discovery and Development. Cell. 2019;176(6):1248-1264. https://doi.org/10.1016/j.cell.2019.01.021
4. Matsumoto K, Ema M. Roles of VEGF-A signalling in development, regeneration, and tumours. J Biochem. 2014;156(1):1-10. https://doi.org/10.1093/jb/mvu031
5. Itatani Y, Kawada K, Yamamoto T, Sakai Y. Resistance to Anti-Angiogenic Therapy in Cancer-Alterations to Anti-VEGF Pathway. Int J Mol Sci. 2018;19(4):1232. Published 2018 Apr 18. doi:10.3390/ijms19041232
6. Uniprot (P15692)
7. Hamilton JL, Nagao M, Levine BR, Chen D, Olsen BR, Im HJ. Targeting VEGF and Its Receptors for the Treatment of Osteoarthritis and Associated Pain. J Bone Miner Res. 2016;31(5):911-924. https://doi.org/10.1002/jbmr.2828
Long Name
Vascular Endothelial Growth Factor
Alternate Names
MVCD1, VAS, Vasculotropin, VEGF-A, VEGFA, VPF
Gene Symbol
VEGFA
Additional VEGF Products
Product Documents for VEGF Antibody (VEGFA/7636R) - Azide and BSA Free
Product Specific Notices for VEGF Antibody (VEGFA/7636R) - Azide and BSA Free
This product is for research use only and is not approved for use in humans or in clinical diagnosis. Primary Antibodies are guaranteed for 1 year from date of receipt.
Loading...
Loading...
Loading...
Loading...
Loading...

